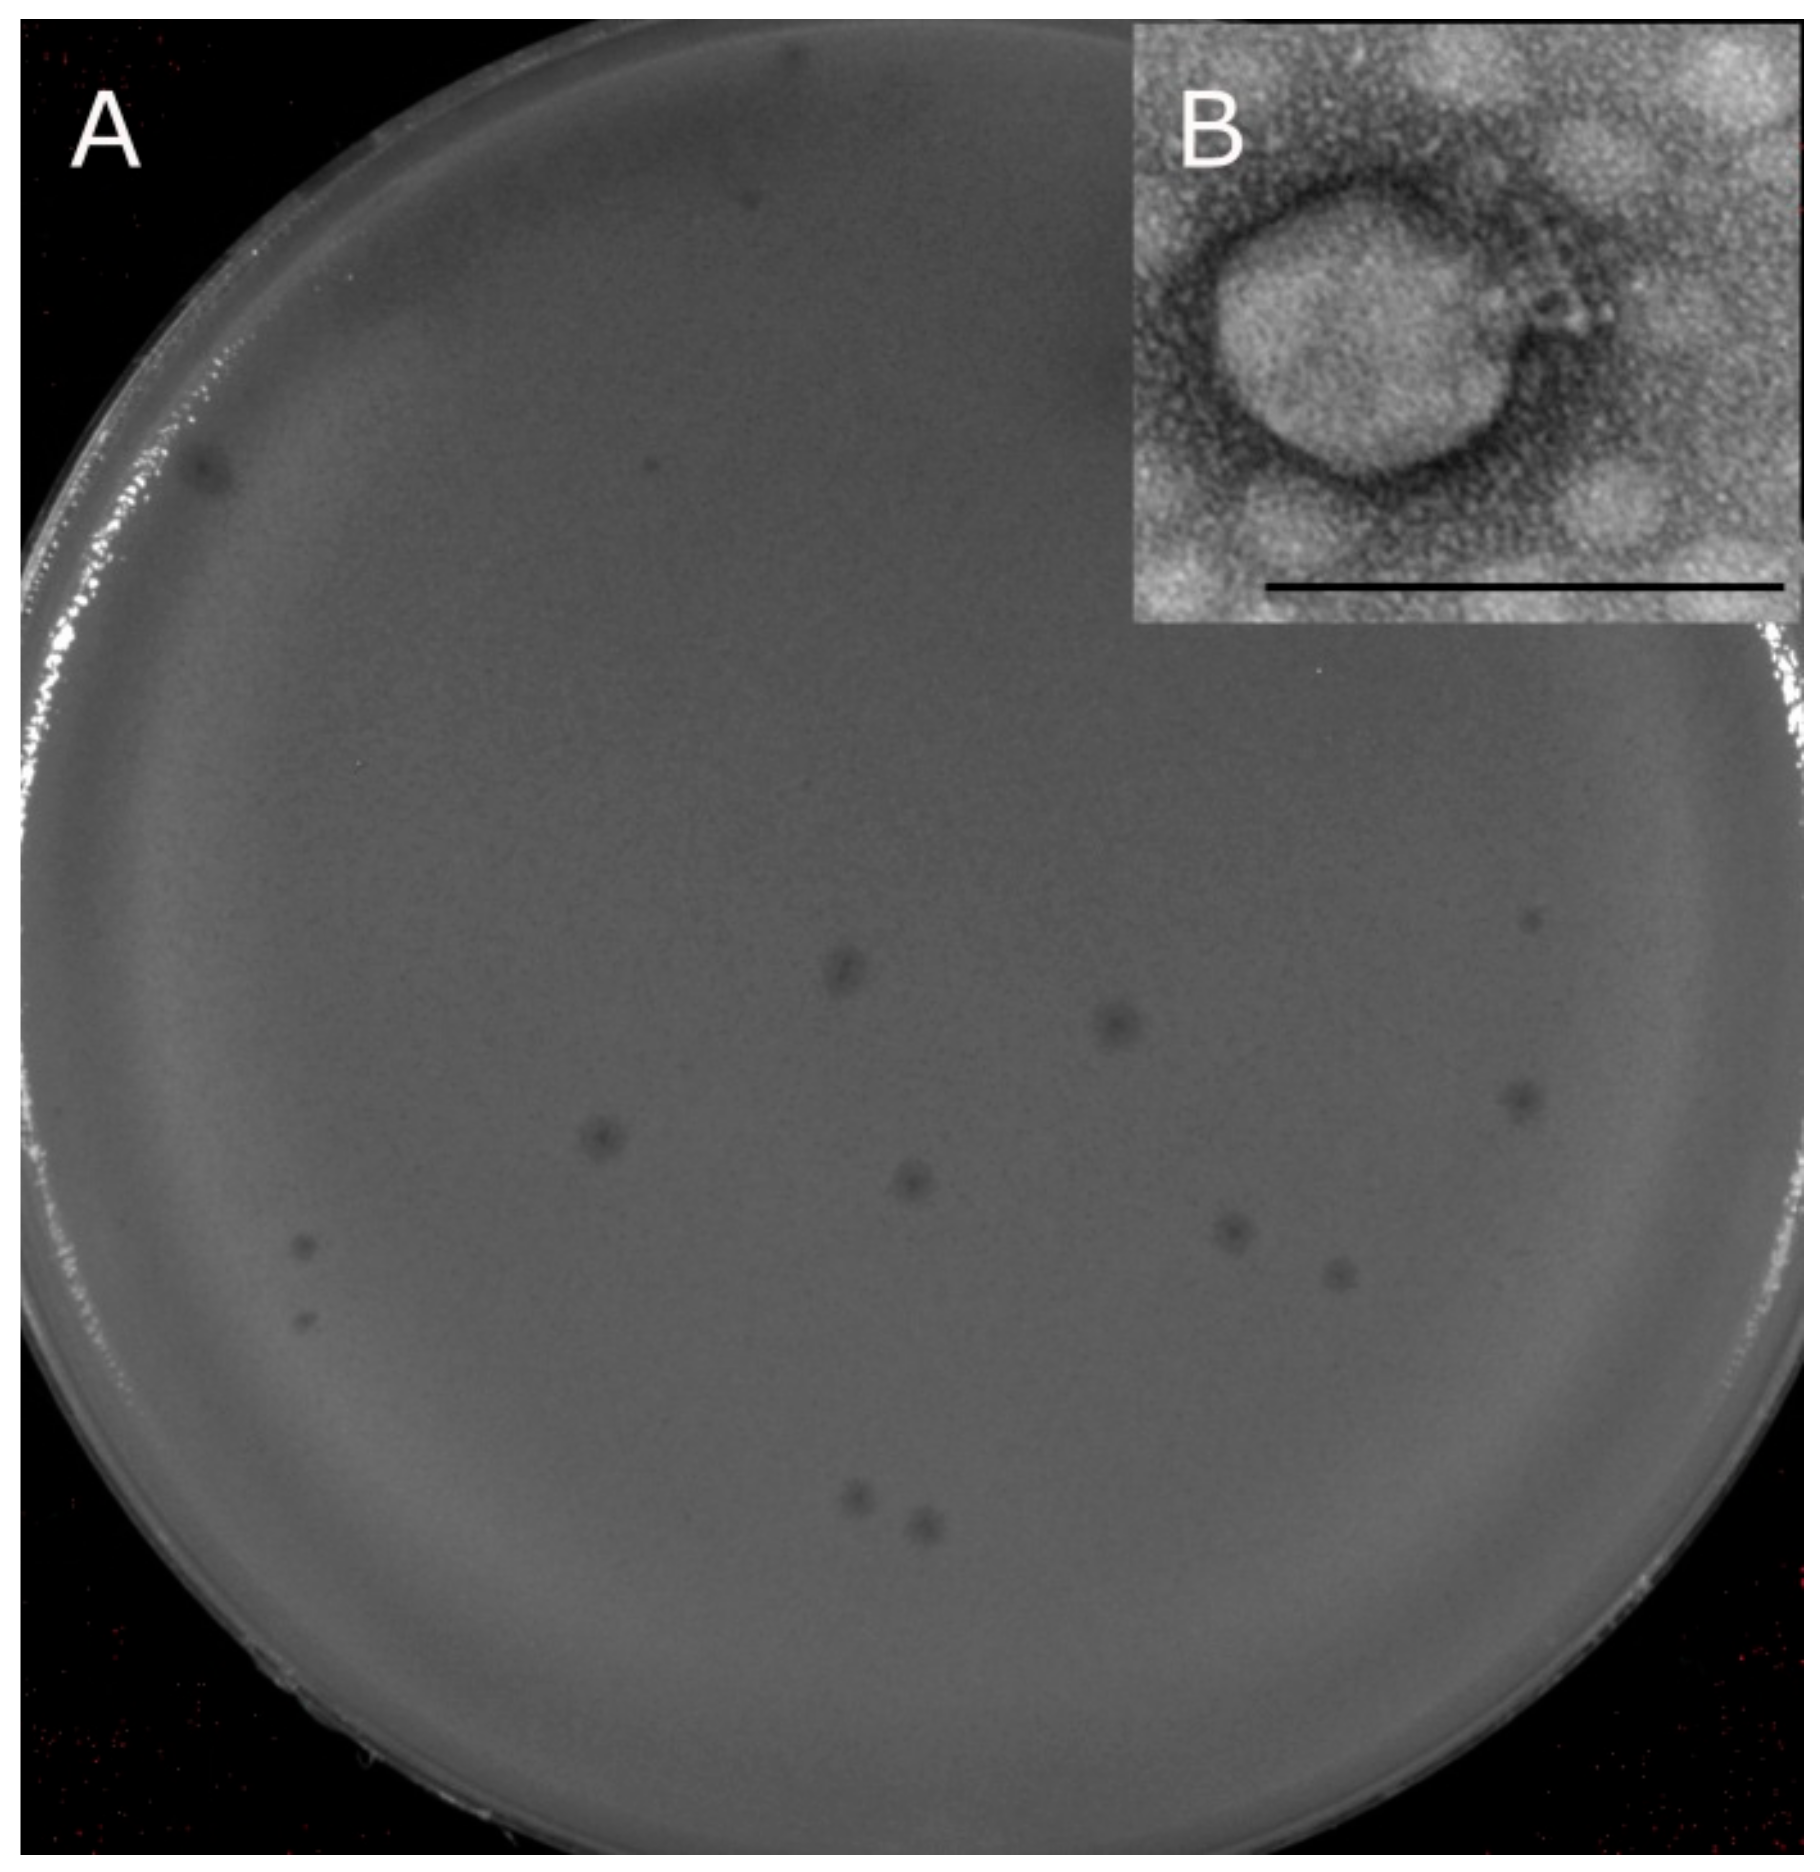
Viruses 11 01115 g002 Viruses 11 01115 g002

Isolation and Characterization of a Novel Klebsiella pneumoniae N4-like Bacteriophage KP8
Abstract
1. Introduction
2. Materials and Methods
2.1. Bacterial Strains and Cultivation Media
2.2. Phage Isolation and Propagation
2.3. Phage Plaque Morphology and Electron Microscopy of Phage Particles
2.4. Biological Properties of KP8 Bacteriophage and Host Range Analysis
2.5. Phage DNA Purification and Sequencing
2.6. Genome Analysis
2.7. Phage Structural Proteins Analysis and Mass Spectrometry
3. Results and Discussion
3.1. Isolation, Morphology, and Host Range
3.2. Biological Properties of KP8
3.3. Genome Structure
3.4. Predicted Gene Products
3.5. Proteomic Analysis
3.6. Phylogenetic Analysis of the KP8 Complete Genome
4. Discussion
Supplementary Materials
Author Contributions
Funding
Acknowledgments
Conflicts of Interest
References
- Vading, M.; Nauclér, P.; Kalin, M.; Giske, C.G. Invasive infection caused by Klebsiella pneumoniae is a disease affecting patients with high comorbidity and associated with high long-term mortality. PLoS ONE 2018, 13, 1–13. [Google Scholar] [CrossRef] [PubMed]
- Yeh, K.M.; Kurup, A.; Siu, L.K.; Koh, Y.L.; Fung, C.P.; Lin, J.C.; Chen, T.L.; Chang, F.Y.; Koh, T.H. Capsular serotype K1 or K2, rather than magA and rmpA, is a major virulence determinant for Klebsiella pneumoniae liver abscess in Singapore and Taiwan. J. Clin. Microbiol. 2007, 45, 466–471. [Google Scholar] [CrossRef] [PubMed]
- Pan, Y.J.; Lin, T.L.; Chen, C.T.; Chen, Y.Y.; Hsieh, P.F.; Hsu, C.R.; Wu, M.C.; Wang, J.T. Genetic analysis of capsular polysaccharide synthesis gene clusters in 79 capsular types of Klebsiella spp. Sci. Rep. 2015, 5, 1–10. [Google Scholar] [CrossRef] [PubMed]
- Salerno, A.; Delétoile, A.; Lefevre, M.; Ciznar, I.; Krovacek, K.; Grimont, P.; Brisse, S. Recombining population structure of Plesiomonas shigelloides (Enterobacteriaceae) revealed by multilocus sequence typing. J. Bacteriol. 2007, 189, 7808–7818. [Google Scholar] [CrossRef]
- Brisse, S.; Passet, V.; Haugaard, A.B.; Babosan, A.; Kassis-Chikhani, N.; Struve, C.; Decré, D. wzi gene sequencing, a rapid method for determination of capsular type for Klebsiella strains. J. Clin. Microbiol. 2013, 51, 4073–4078. [Google Scholar] [CrossRef]
- Munoz-Price, L.S.; Poirel, L.; Bonomo, R.A.; Schwaber, M.J.; Daikos, G.L.; Cormican, M.; Cornaglia, G.; Garau, J.; Gniadkowski, M.; Hayden, M.K.; et al. Clinical epidemiology of the global expansion of Klebsiella pneumoniae carbapenemases. Lancet Infect. Dis. 2013, 13, 785–796. [Google Scholar] [CrossRef]
- Wei, J.; Wenjie, Y.; Ping, L.; Na, W.; Haixia, R.; Xuequn, Z. Antibiotic resistance of Klebsiella pneumoniae through β-arrestin recruitment-induced β-lactamase signaling pathway. Exp. Ther. Med. 2018, 15, 2247–2254. [Google Scholar] [CrossRef]
- Pitout, J.D.; Nordmann, C.; Poirel, L. Carbapenemase-Producing Klebsiella pneumoniae, a Key Pathogen Set for Global Nosocomial Dominance. Antimicrob. Agents Chemother. 2015, 59, 5873–5884. [Google Scholar] [CrossRef]
- Anderson, D.J.; Moehring, R.W.; Sloane, R.; Schmader, K.E.; Weber, D.J.; Fowler, V.G., Jr.; Smathers, E.; Sexton, D.J. Bloodstream infections in community hospitals in the 21st century: A multicenter cohort study. PLoS ONE 2014, 9, 1–10. [Google Scholar] [CrossRef]
- Iredell, J.; Brown, J.; Tagg, K. Antibiotic resistance in Enterobacteriaceae: Mechanisms and clinical implications. BMJ 2016, 352, 1–19. [Google Scholar] [CrossRef]
- Tamura, K.; Stecher, G.; Peterson, D.; Filipski, A.; Kumar, S. MEGA 6: Molecular Evolutionary Genetics Analysis version 6.0. Mol. Biol. Evol. 2013, 30, 2725–2729. [Google Scholar] [CrossRef] [PubMed]
- Morozova, V.; Kozlova, Y.; Shedko, E.; Kurilshikov, A.; Babkin, I.; Tupikin, A.; Yunusova, A.; Chernonosov, A.; Baykov, I.; Kondratov, I. Lytic Bacteriophage PM16 Specific for Proteus mirabilis: A Novel Member of the genus phiKMVvirus. Arch. Virol. 2016, 161, 2457–2472. [Google Scholar] [CrossRef] [PubMed]
- Sambrook, J.; Russell, D.W. Molecular Cloning: A Laboratory Manual, 3rd ed.; Cold Spring Harbor Laboratory Press: Cold Spring Harbor, NY, USA, 2001; pp. 187–303. [Google Scholar]
- Kropinski, A.M.; Mazzocco, A.; Waddell, T.E.; Lingohr, E.; Johnson, R.P. Enumeration of bacteriophages by double agar overlay plaque assay. In Bacteriophages: Methods and Protocols; Clokie, M.R.J., Kropinski, A.M., Eds.; Humana Press: New York, NY, USA, 2009; pp. 69–76. [Google Scholar]
- Pajunen, M.; Kiljunen, S.; Skurnik, M. Bacteriophage phiYeO3-12, specific for Yersinia enterocolitica serotype O:3, is related to coliphages T3 and T7. J. Bacteriol. 2000, 182, 5114–5120. [Google Scholar] [CrossRef] [PubMed]
- Heo, Y.J.; Lee, Y.R.; Jung, H.H.; Lee, J.; Ko, G.; Cho, Y.H. Antibacterial Efficacy of phages against Pseudomonas aeruginosa infections in mice and Drosophila melanogaster. Antimicrob Agents Chemother. 2009, 53, 2469–2474. [Google Scholar] [CrossRef] [PubMed]
- Kutter, E. Phage Host Range and Efficiency of Plating. In Bacteriophages: Methods and Protocols; Clokie, M.R.J., Kropinski, A.M., Eds.; Humana Press: New York, NY, USA, 2009; pp. 141–149. [Google Scholar]
- O’Flaherty, S.; Coffey, A.; Edwards, R.; Meaney, W.; Fitzgerald, G.F.; Ross, R.P. Genome of staphylococcal phage K: A new lineage of Myoviridae infecting gram-positive bacteria with a low GC content. J. Bacteriol. 2004, 186, 2862–2871. [Google Scholar] [CrossRef] [PubMed]
- Aziz, R.K.; Bartels, D.; Best, A.A.; DeJongh, M.; Disz, T.; Edwards, R.A.; Formsma, K.; Gerdes, S.; Glass, E.M.; Kubal, M.; et al. The RAST Server: Rapid Annotations using Subsystems Technology. BMC Genomics 2008, 9, 75. [Google Scholar] [CrossRef]
- Jones, P.; Binns, D.; Chang, H.-Y.; Fraser, M.; Li, W.; McAnulla, C.; McWilliam, H.; Maslen, J.; Mitchell, A.; Nuka, G.; et al. InterProScan 5: Genome-scale protein function classification. Bioinformatics 2014, 30, 1236–1240. [Google Scholar] [CrossRef]
- Remmert, M.; Biegert, A.; Hauser, A.; Söding, J. HHblits: Lightning-fast iterative protein sequence searching by HMM-HMM alignment. Nat. Methods 2011, 9, 173–175. [Google Scholar] [CrossRef]
- Lowe, T.M.; Chan, P.P. tRNAscan-SE On-line: Integrating search and context for analysis of transfer RNA genes. Nucleic Acids Res. 2012, 44, 54–57. [Google Scholar] [CrossRef]
- Laslett, D.; Canback, B. ARAGORN, a program to detect tRNA genes and tmRNA genes in nucleotide sequences. Nucleic Acids Res. 2004, 32, 11–16. [Google Scholar] [CrossRef]
- Käll, L.; Krogh, A.; Sonnhammer, E.L. Advantages of combined transmembrane topology and signal peptide prediction—The Phobius web server. Nucleic Acids Res. 2007, 35, W429–W432. [Google Scholar] [CrossRef] [PubMed]
- Haynes, L.L.; Rothman-Denes, L.B. N4 virion RNA polymerase sites of transcription initiation. Cell 1985, 41, 597–605. [Google Scholar] [CrossRef]
- Lu, G.; Moriyama, E.N. Vector NTI, a balanced all-in-one sequence analysis suite. Brief. Bioinform. 2004, 5, 378–388. [Google Scholar] [CrossRef] [PubMed]
- Darling, A.C.; Mau, B.; Blattner, F.R.; Perna, N.T. Mauve: Multiple alignment of conserved genomic sequence with rearrangements. Genome Res. 2004, 14, 1394–1403. [Google Scholar] [CrossRef]
- Phillips, J.L.; Gnanakaran, S. BioEdit: An important software for molecular biology. Proteins Struct Funct. Bioinform. 2015, 83, 46–65. [Google Scholar] [CrossRef]
- Shevchenko, A.; Jensen, O.N.; Podtelejnikov, A.V.; Sagliocco, F.; Wilm, M.; Vorm, O.; Mortensen, P.; Shevchenko, A.; Boucherie, H.; Mann, M. Linking genome and proteome by mass spectrometry: Large-scale identification of yeast proteins from two dimensional gels. Proc. Natl. Acad. Sci. USA 1996, 93, 14440–14445. [Google Scholar] [CrossRef]
- Niedermeyer, T.H.J.; Strohalm, M. mMass as a Software Tool for the Annotation of Cyclic Peptide Tandem Mass Spectra. PLoS ONE 2012, 7, e44913. [Google Scholar] [CrossRef]
- Ackermann, H.W. Phage Classification and Characterization. In Bacteriophages: Methods and Protocols; Clokie, M.R.J., Kropinski, A.M., Eds.; Humana Press: New York, NY, USA, 2009; pp. 127–140. [Google Scholar] [CrossRef]
- Pan, Y.; Lin, T.; Lin, Y.; Su, P.; Chen, C.; Hsieh, P.; Hsu, C.; Chen, C.; Hsieh, Y.; Wang, J. Identification of capsular types in carbapenem-resistant Klebsiella pneumoniae strains by wzc sequencing and implications for capsule depolymerase treatment. Antimicrob. Agents Chemother. 2015, 59, 1038–1047. [Google Scholar] [CrossRef]
- Ohmori, H.; Haynes, L.L.; Rothman-Denes, L.B. Structure of the ends of the coliphage N4 genome. J. Mol. Biol. 1988, 202, 1–10. [Google Scholar] [CrossRef]
- Kulikov, E.; Kropinski, A.M.; Golomidova, A.; Lingohr, E.; Govorun, V.; Serebryakova, M.; Prokhorov, N.; Letarova, M.; Manykin, A.; Strotskaya, A.; et al. Isolation and characterization of a novel indigenous intestinal N4-related coliphage vB_EcoP_G7C. Virology 2012, 426, 93–99. [Google Scholar] [CrossRef]
- Nho, S.W.; Ha, M.A.; Kim, K.S.; Kim, T.H.; Jang, H.B.; Cha, I.S.; Park, S.B.; Kim, Y.K.; Jung, T.S. Complete genome sequence of the bacteriophages ECBP1 and ECBP2 isolated from two different Escherichia coli strains. J. Virol. 2012, 86, 12439–12440. [Google Scholar] [CrossRef][Green Version]
- Gan, H.M.; Sieo, C.C.; Tang, S.G.; Omar, A.R.; Ho, Y.W. The complete genome sequence of EC1-UPM, a novel N4-like bacteriophage that infects Escherichia coli O78:K80. Virol. J. 2013, 10, 308. [Google Scholar] [CrossRef] [PubMed]
- Jun, J.W.; Yun, S.K.; Kim, H.J.; Chai, J.Y.; Park, S.C. Characterization and complete genome sequence of a novel N4-like bacteriophage, pSb-1 infecting Shigella boydii. Res. Microbiol. 2014, 165, 671–678. [Google Scholar] [CrossRef] [PubMed]
- Tsonos, J.; Oosterik, L.H.; Tuntufye, H.N.; Klumpp, J.; Butaye, P.; De Greve, H.; Hernalsteens, J.P.; Lavigne, R.; Goddeeris, B.M. A cocktail of in vitro efficient phages is not a guarantee for in vivo therapeutic results against avian colibacillosis. Vet. Microbiol. 2014, 171, 470–479. [Google Scholar] [CrossRef] [PubMed]
- Fan, H.; Fan, H.; An, X.; Huang, Y.; Zhang, Z.; Mi, Z.; Tong, Y. Complete genome sequence of IME11, a new N4-like bacteriophage. J. Virol. 2012, 86, 13861. [Google Scholar] [CrossRef] [PubMed][Green Version]
- Wittmann, J.; Dreiseikelmann, B.; Rohde, M.; Meier-Kolthoff, J.P.; Bunk, B.; Rohde, C. First genome sequences of Achromobacter phages reveal new members of the N4 family. Virol J. 2014, 11, 14. [Google Scholar] [CrossRef]
- Park, J.; Lee, G.M.; Kim, D.; Park, D.H.; Oh, C.S. Characterization of the lytic bacteriophage phiEaP-8 effective against both Erwinia amylovora and Erwinia pyrifoliae causing severe diseases in apple and pear. Plant. Pathol. J. 2018, 34, 445–450. [Google Scholar] [CrossRef]
- Ankrah, N.Y.; Budinoff, C.R.; Wilson, W.H.; Wilhelm, S.W.; Buchan, A. Genome sequence of the Sulfitobacter sp. strain 2047-infecting lytic phage {Phi}CB2047-B. Genome Announc. 2014, 2, e00945-13. [Google Scholar] [CrossRef]
- Chan, J.Z.; Millard, A.D.; Mann, N.H.; Schäfer, H. Comparative genomics defines the core genome of the growing N4-like phage genus and identifies N4-like Roseophage specific genes. Front. Microbiol. 2014, 5, 506. [Google Scholar] [CrossRef]
- Zhao, Y.; Wang, K.; Jiao, N.; Chen, F. Genome sequences of two novel phages infecting marine roseobacters. Environ. Microbiol. 2009, 11, 2055–2064. [Google Scholar] [CrossRef]
- Moreno Switt, A.I.; Orsi, R.H.; den Bakker, H.C.; Vongkamjan, K.; Altier, C.; Wiedmann, M. Genomic characterization provides new insight into Salmonella phage diversity. BMC Genomics 2013, 14, 481. [Google Scholar] [CrossRef] [PubMed]
- Ceyssens, P.J.; Brabban, A.; Rogge, L.; Lewis, M.S.; Pickard, D.; Goulding, D.; Dougan, G.; Noben, J.P.; Kropinski, A.; Kutter, E.; et al. Molecular and physiological analysis of three Pseudomonas aeruginosa phages belonging to the “N4-like viruses”. Virology 2010, 405, 26–30. [Google Scholar] [CrossRef] [PubMed]
- Wittmann, J.; Klumpp, J.; Moreno Switt, A.I.; Yagubi, A.; Ackermann, H.W.; Wiedmann, M.; Svircev, A.; Nash, J.H.; Kropinski, A.M. Taxonomic reassessment of N4-like viruses using comparative genomics and proteomics suggests a new subfamily—“Enquartavirinae”. Arch. Virol. 2015, 160, 3053–3062. [Google Scholar] [CrossRef] [PubMed]

| Name | Position | ORF a | Regulatory Element Sequence b |
|---|---|---|---|
| Putative promoter | |||
| P1 | 89–110 | 1 | ACGTTGCTCCGCAACCTATGGA |
| P2 | 962–983 | 4 | AAGACGCTCCGCGTCTTATGGA |
| P3 | 1225–1246 | 5 | GGGCTGCTCCGCAGCCTTTGGA |
| P4 | 5965–5984 | 21 | AAGCAGCTCCGCTGCTTGTGGG |
| Putative ρ-independent terminator | |||
| T | 37311–37349 | 64 | TGCTGAAGAATGGGCAAGTAGTGCCTTAGAGCGACCTTG |
| No | ORF | ORF Position (b.p.) | Length of Product (aa)/Predicted Molecular Mass (kDa) | Start Codon/ORF Orientation (+−) | Maximal Identity (%) with GenBank Phage Protein Sequences, according to Algorithm BLASTXa | Predicted Molecular Function | Protein Sequence Coverage, (%) in MS-Analysis |
|---|---|---|---|---|---|---|---|
| 1 | 5 | 1254–1748 | 165/18.2 | ATG/+ | 74.2 (Escherichia virus N4 [YP_950480]) | RNA polymerase 1 subunit A | |
| 2 | 14 | 3799–4155 | 119/13.3 | ATG/+ | 75.4 (Escherichia phage EC1-UPM [YP_009598285]) | GTP binding protein DUF2493/DNA processing A domain | |
| 3 | 19 | 5304–5684 | 126/13.89 | ATG/+ | 77.0 (Escherichia virus N4 [YP_950492]) | ADP-ribosylglycohydrolase | |
| 4 | 22 | 6257–7072 | 272/31.73 | ATG/+ | 74.6 (Escherichia virus N4 [YP_950493]) | RNA polymerase 1 subunit B | |
| 5 | 25 | 7589–8803 | 404/45.99 | ATG/+ | 74.1 (Escherichia phage PMBT57 [AUV59092]) | RNA polymerase 2 subunit A | |
| 6 | 26 | 8896–9411 | 171/17.95 | ATG/+ | 48.5 (Erwinia phage phiEaP-8 [AWN06248]) | Capsid decorating protein (Ig-like domain) | 84 |
| 7 | 29 | 10082–10432 | 116/13.24 | ATG/+ | 88.4 (Escherichia virus N4 [YP_950500]) | HNH-endonuclease | |
| 8 | 35 | 11890–12942 | 350/35.9 | ATG/+ | 63.0 (Escherichia phage OLB145 [AYR04207]) | ATPase | |
| 9 | 36 | 12953–14104 | 384/43.8 | ATG/+ | 62.9 (Escherichia phage OLB145 [AYR04209]) | Metallopeptidase | |
| 10 | 37 | 14112–14639 | 175/19.5 | ATG/+ | 78.7 (Escherichia phage phiG17 [AWY03411]) | dCTP deaminase | |
| 11 | 40 | 15353–16294 | 313/35.9 | ATG/+ | 67.7 (Escherichia phage PMBT57 [AUV59106]) | FAD-dependent thymidylate synthase | |
| 12 | 44 | 17167–19689 | 840/95.1 | ATG/+ | 43.5 (Escherichia virus N4 [YP_950511]) | rIIA lysis inhibitor | |
| 13 | 45 | 19686–21722 | 678/73.69 | ATG/+ | 52.7 (Escherichia virus N4 [YP_950512]) | rIIB lysis inhibitor | |
| 14 | 46 | 21782–22177 | 131/14.9 | ATG/+ | 84.6 (Escherichia phage PMBT57 [AUV59111]) | DNA-binding domain1 | |
| 15 | 47 | 22158–22562 | 134/14.8 | GTG/+ | 64.4 (Escherichia phage vB_EcoP_PhAPEC5 [YP_009055545]) | NTP pyrophosphohydrolase | |
| 16 | 48 | 22599–23906 | 435/49.05 | ATG/+ | 71.3 (Escherichia virus N4 [YP_950515]) | DNA-helicase | |
| 17 | 50 | 24454–27036 | 860/97.5 | ATG/+ | 74.8 (Escherichia phage vB_EcoP_G7C [YP_004782168.1]) | DNA-polymerase I | |
| 18 | 51 | 27036–27251 | 71/7.88 | ATG/+ | 47.0 (Klebsiella phage Soft [QEM42165.1]) | Nucleoside/nucleotide kinase1 | |
| 19 | 53 | 27556–27966 | 136/15.34 | ATG/+ | 79.8 (Escherichia virus N4 [YP_950519.1]) | 3’-phosphatase 5’-polynucleotide kinase | |
| 20 | 54 | 27950–28921 | 323/37.33 | GTG/+ | 78.0 (Escherichia virus N4 [YP_950520.1]) | PD-(D/E)XK nuclease superfamily protein | |
| 21 | 55 | 28921–31068 | 715/81.8 | ATG/+ | 80.7 (Escherichia phage PMBT57 [AUV59047]) | DNA primase | |
| 22 | 56 | 31126–31884 | 252/28.68 | ATG/+ | 86.9 (Escherichia phage PGN829.1 [AXY82607.1]) | Nucleoside triphosphate hydrolase | |
| 23 | 57 | 31927–32721 | 264/28.45 | ATG/+ | 57.7 (Escherichia virus N4 [YP_950523.1]) | ssDNA-binding protein | |
| 24 | 58 | 32721–33278 | 185/20.3 | ATG/+ | 73.5 (Escherichia virus N4 [YP_950524.1]) | Holliday junction resolvase | |
| 25 | 68 | 37968–48392 | 3474/379.07 | ATG/− | 69.9 (Escherichia phage OLB145 [AYR04234.1]) | Virion RNA polymerase | 8 |
| 26 | 69 | 48494–50443 | 649/70 | ATG/− | 69.3 (Escherichia phage vB_EcoP_PhAPEC7 [YP_009056187.1]) | Putative structural protein | 78 |
| 27 | 70 | 50453–50893 | 146/15.5 | ATG/− | 66.4 (Escherichia phage ECBP1 [YP_006908829]) | Putative structural protein | |
| 28 | 72 | 53569–54399 | 276/30.3 | ATG/− | 85.6 (Escherichia phage IME11 [YP_006990617]) | Putative structural protein | |
| 29 | 74 | 55147–56352 | 401/44.1 | ATG/− | 90.5 (Escherichia phage vB_EcoP_PhAPEC5 [YP_009055570.1) | Major coat protein | 91 |
| 30 | 75 | 56365–57594 | 409/45 | ATG/− | 66.3 (Escherichia phage IME11 [YP_006990614]) | Tape measure protein | |
| 31 | 77 | 57976–60261 | 761/85.1 | ATG/− | 76.9 (Escherichia phage PGN829 [AXY82589]) | Portal protein | 57 |
| 32 | 78 | 60270–60767 | 165/18.8 | ATG/− | 65.9 (Escherichia phage IME11 [YP_006990611]) | Rz/RzI spanin protein | |
| 33 | 79 | 60751–61389 | 212/22.8 | ATG/− | 81.8 (Escherichia phage vB_EcoP_PhAPEC7 [YP_009056197]) | N-acetylmuramidase | |
| 34 | 80 | 61373–61699 | 108/12.6 | ATG/− | 56.6 (Shigella phage pSb-1 [YP_009008416]) | Holin | |
| 35 | 81 | 61624–61956 | 110/12.3 | ATG/− | 97.8 (Escherichia phage IME11 [YP_006990608]) | Tail length tape-measure protein | |
| 36 | 83 | 62259–64526 | 755/82.25 | ATG/− | 23.7 (Klebsiella phage K64-1 [YP_009153195]) | Tail spike protein/endo-N-acetylneuraminidase | 64 |
| 37 | 84 | 64598–67075 | 825/89.3 | ATG/− | 30.1 (Escherichia phage IME11 [YP_006990695]) | Tail fiber protein/SGNH-esterase domain 1 | 56 |
| 38 | 85 | 67072–67779 | 235/61 | ATG/− | 97.0 (Escherichia phage IME11 [YP_006990694]) | Head completion adaptor | |
| 39 | 86 | 67786–69378 | 530/60.7 | ATG/− | 89.4 (Escherichia virus N4 [YP_950546]) | Terminase large subunit | |
| 40 | 87 | 69371–70063 | 230/25.6 | ATG/− | 86.1 (Escherichia virus N4 [YP_950547]) | Terminase small subunit |
© 2019 by the authors. Licensee MDPI, Basel, Switzerland. This article is an open access article distributed under the terms and conditions of the Creative Commons Attribution (CC BY) license (http://creativecommons.org/licenses/by/4.0/).
Share and Cite
Morozova, V.; Babkin, I.; Kozlova, Y.; Baykov, I.; Bokovaya, O.; Tikunov, A.; Ushakova, T.; Bardasheva, A.; Ryabchikova, E.; Zelentsova, E.; et al. Isolation and Characterization of a Novel Klebsiella pneumoniae N4-like Bacteriophage KP8. Viruses 2019, 11, 1115. https://doi.org/10.3390/v11121115
Morozova V, Babkin I, Kozlova Y, Baykov I, Bokovaya O, Tikunov A, Ushakova T, Bardasheva A, Ryabchikova E, Zelentsova E, et al. Isolation and Characterization of a Novel Klebsiella pneumoniae N4-like Bacteriophage KP8. Viruses. 2019; 11(12):1115. https://doi.org/10.3390/v11121115
Chicago/Turabian StyleMorozova, Vera, Igor Babkin, Yuliya Kozlova, Ivan Baykov, Olga Bokovaya, Artem Tikunov, Tatyana Ushakova, Alevtina Bardasheva, Elena Ryabchikova, Ekaterina Zelentsova, and et al. 2019. "Isolation and Characterization of a Novel Klebsiella pneumoniae N4-like Bacteriophage KP8" Viruses 11, no. 12: 1115. https://doi.org/10.3390/v11121115
APA StyleMorozova, V., Babkin, I., Kozlova, Y., Baykov, I., Bokovaya, O., Tikunov, A., Ushakova, T., Bardasheva, A., Ryabchikova, E., Zelentsova, E., & Tikunova, N. (2019). Isolation and Characterization of a Novel Klebsiella pneumoniae N4-like Bacteriophage KP8. Viruses, 11(12), 1115. https://doi.org/10.3390/v11121115

